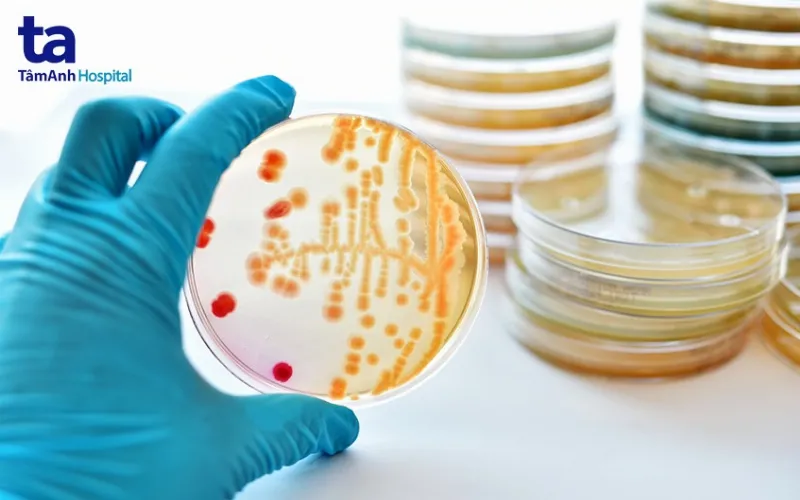
Vi khuẩn gây bệnh

Viêm bể thận cấp là một bệnh nhiễm trùng đường tiết niệu do vi khuẩn gây ra. Bệnh tiến triển nhanh và có thể gây ra nhiều biến chứng nguy hiểm nếu không được phát hiện và điều trị kịp thời. Bài viết này sẽ cung cấp thông tin chi tiết về viêm bể thận cấp, bao gồm nguyên nhân, triệu chứng, cách chẩn đoán và phương pháp điều trị.
 Viêm bể thận cấp
Viêm bể thận cấp
Tào quan là một vấn đề sức khỏe khác, bạn có thể tìm hiểu thêm.
Viêm Bể Thận Cấp là gì?
Viêm bể thận cấp, hay còn gọi là nhiễm trùng đường tiết niệu trên, là tình trạng nhiễm khuẩn cấp tính xảy ra khi vi khuẩn tấn công các đài thận, bể thận, niệu quản và nhu mô thận. Vi khuẩn có thể di chuyển từ bàng quang lên niệu quản hoặc xâm nhập qua đường máu. Bệnh thường khởi phát đột ngột với các triệu chứng viêm toàn thân, kèm theo đau dữ dội vùng hông lưng. Tuy nhiên, nếu phát hiện sớm, bệnh có thể được điều trị ngoại trú bằng kháng sinh.
 Viêm bể thận cấp là gì?
Viêm bể thận cấp là gì?
Triệu Chứng của Viêm Bể Thận Cấp
Các triệu chứng của viêm bể thận cấp thường xuất hiện trong vòng 2 ngày sau khi nhiễm khuẩn, bao gồm:
- Sốt cao trên 38,9°C
- Đau bụng, lưng, hông hoặc bẹn
- Tiểu buốt, tiểu rát, tiểu gấp, tiểu nhiều lần
- Nước tiểu đục, có mủ hoặc máu, có mùi tanh
Ngoài ra, còn có thể xuất hiện các triệu chứng khác như:
- Lạnh run hoặc ớn lạnh
- Buồn nôn, nôn mửa
- Đau vùng sườn lưng một hoặc hai bên, lan xuống bàng quang và bộ phận sinh dục ngoài
- Sờ thấy thận to, ấn vào đau nhói
Tuy nhiên, khoảng 20% bệnh nhân không có triệu chứng về bàng quang, và một số bệnh nhân không sốt hoặc không đau. Bệnh thường nặng hơn ở những người suy giảm miễn dịch, tắc nghẽn đường tiết niệu, phụ nữ mang thai và người trên 65 tuổi. Bạn đã biết ý trung nhân là gì chưa?
 banner khai trương tâm anh quận 8 mb
banner khai trương tâm anh quận 8 mb
Nguyên Nhân Gây Viêm Bể Thận Cấp
Viêm bể thận cấp thường bắt đầu từ nhiễm trùng đường tiết niệu dưới. Vi khuẩn xâm nhập qua niệu đạo, nhân lên ở bàng quang, sau đó di chuyển lên thận qua niệu quản. Nguyên nhân chủ yếu là vi khuẩn Gram âm như E. coli. Các yếu tố làm tăng nguy cơ mắc bệnh bao gồm:
- Nhiễm trùng tiết niệu dưới
- Phẫu thuật hệ tiết niệu
- Tắc nghẽn đường tiết niệu (sỏi, u…)
- Các ổ viêm nhiễm (phụ khoa, tuyến tiền liệt, trực tràng, bàng quang…)
Vi khuẩn gây bệnh
Vi khuẩn gây bệnh
Biến Chứng của Viêm Bể Thận Cấp
Viêm bể thận cấp có thể gây ra nhiều biến chứng nguy hiểm nếu không được điều trị kịp thời:
- Áp xe thận
- Nhiễm khuẩn huyết
- Suy thận cấp
- Hoại tử nhú thận
- Kháng kháng sinh
- Viêm bể thận mạn, suy thận mạn
Đồ cúng thần tài là một chủ đề thú vị khác.
Chẩn Đoán Viêm Bể Thận Cấp
Việc chẩn đoán viêm bể thận cấp dựa trên khám lâm sàng và xét nghiệm:
1. Lâm sàng:
Bác sĩ sẽ đánh giá các triệu chứng như sốt, rét run, đau hông lưng, tiểu buốt, tiểu dắt, tiểu máu…
2. Cận lâm sàng:
- Xét nghiệm công thức máu (bạch cầu tăng)
- Cấy máu, cấy nước tiểu
- Siêu âm
- Chụp X-quang bàng quang (nếu nghi ngờ trào ngược bàng quang – thận)
 Chẩn đoán cận lâm sàng
Chẩn đoán cận lâm sàng
Điều Trị Viêm Bể Thận Cấp
Tùy vào mức độ nặng nhẹ, viêm bể thận cấp có thể được điều trị ngoại trú hoặc nội trú:
1. Kháng sinh:
Điều trị ngoại trú thường dùng kháng sinh đường uống trong 1-14 ngày. Nếu tình trạng không cải thiện, cần chuyển sang điều trị nội trú. Mâm cúng đầy tháng cho bé trai cũng là một chủ đề quan trọng.
2. Điều trị nội trú:
Áp dụng cho trường hợp nặng, phụ nữ mang thai hoặc người có bệnh lý nền.
3. Phẫu thuật:
Chỉ được thực hiện trong trường hợp tắc nghẽn thận hoặc sốc nhiễm khuẩn.
Phòng Ngừa Viêm Bể Thận Cấp
Một số biện pháp phòng ngừa viêm bể thận cấp bao gồm:
- Giữ vệ sinh cơ quan sinh dục – tiết niệu
- Uống đủ nước
- Điều trị sớm các nhiễm trùng tiết niệu và tắc nghẽn đường tiết niệu
- Khám sức khỏe định kỳ
Văn khấn cúng mụ cho bé trai là một thông tin hữu ích khác.
Kết luận
Viêm bể thận cấp là bệnh lý nguy hiểm nhưng có thể phòng ngừa và điều trị hiệu quả nếu được phát hiện sớm. Hãy đến gặp bác sĩ ngay khi có các triệu chứng nghi ngờ để được chẩn đoán và điều trị kịp thời.

